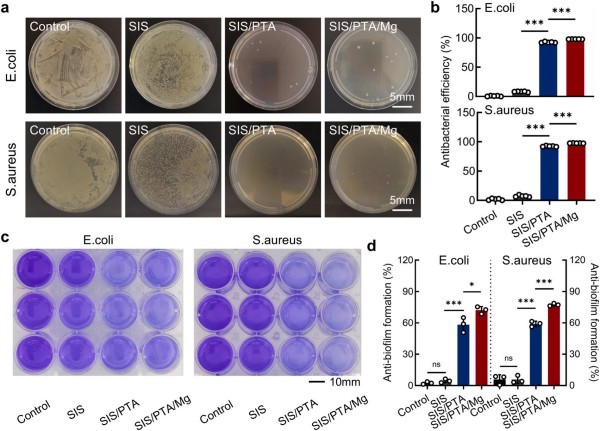
图片3-抗菌评价.jpg

腹壁损伤是临床常见问题,多由创伤、手术干预或先天性异常引发,发病率逐年攀升。据数据统计,全球每年腹壁疝发生率为4-5%,而腹部手术后切口疝发生率高达20%。这类损伤不仅破坏腹腔结构完整性,还可能引发疼痛、器官功能障碍等并发症,严重时甚至导致肠梗阻、脓毒症等危及生命的情况。
腹壁损伤的治疗过程复杂,传统方法如手术缝合或合成补片植入往往收效甚微,尤其在感染或组织整合不良的情况下。此外,疝气修补中使用合成补片的相关并发症发生率高达 30%,包括感染、免疫排斥和组织生长不良等问题。这些并发症往往需要患者接受反复手术、延长住院时间并进行长期护理,既加重了患者的身心负担,也给临床医疗带来挑战。因此,开发一种兼具结构支撑与治疗功能的先进材料——既能提供稳定机械支撑、促进组织再生,还能有效抵御细菌污染,成为应对腹壁损伤治疗难题的关键突破口。

图为:文章首页

图为:实验设计思路
针对这一临床痛点,博辉瑞进联合武汉大学中南医院专家团队,借助公司自主创新研发的猪小肠黏膜下层脱细胞外基质(SIS)材料平台技术,开发了一种以SIS材料为基底的复合生物补片(SIS/PTA/Mg)。其表面包覆聚单宁酸(PTA)和镁离子(Mg²⁺) , 赋予补片强效抗菌性能、强大促血管生成和组织再生能力,并通过体外、体内实验验证了该补片的优异性能。
在体外实验中,SIS/PTA/Mg生物补片在L929细胞增殖和存活实验中表现出优异的生物相容性,同时对大肠杆菌、金黄色葡萄球菌展现出显著的抗菌效果。

图为:基于ISO10993标准的生物相容性研究
图为:SIS/PTA/Mg生物补片的抗菌性能研究
动物模型实验进一步证实,SIS/PTA/Mg生物补片在腹壁损伤修复中显示出显著的抗感染效果,同时有效促进血管生成并加速伤口愈合。通过调节局部微环境,PTA与Mg²⁺的联合应用不仅克服了传统修复材料在抗菌和再生性能方面的局限,还显著提升了修复效果的持久性和稳定性。

图为:SIS/PTA/Mg生物补片在腹壁缺损模型中的抗菌效果评估

图为:使用SIS/PTA/Mg生物补片评估腹壁修复
这些令人欣喜的结果表明,SIS/PTA/Mg生物补片为临床腹壁损伤修复提供了新型高效解决方案,未来在其他软组织损伤治疗中也具有广阔应用前景。
目前,相关研究成果以《Antibacterial and pro-angiogenic SIS-based bio-patches with poly(tannic acid) and magnesium facilitating abdominal wall repair》为题,已正式发表于材料科学领域权威期刊《Materials & Design》,影响因子7.9。

《中国肺癌杂志》2024年6月第27卷第...

2024年12月6日,为期三天的SDHE...

理智弄槽外科韵,巴山蜀水天府情。2024...

近日,《中华胸心血管外科杂志》2024年...

2024年5月9日,在VBEF未来医疗生...

新春伊始,万象更新。博辉瑞进迎来新春“开...
版权所有北京博辉瑞进生物科技股份有限公司 京ICP备16026579号 (京)-非经营性-2017-0030  京公网安备 11011502006176号 药品医疗器械网络信息服务备案(京)网药械信息备字(2022)第00096号
京公网安备 11011502006176号 药品医疗器械网络信息服务备案(京)网药械信息备字(2022)第00096号